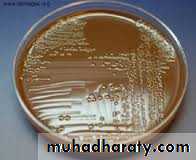

Family Neisseriaceae
Dr. Nada A. HassoPh.D Medical MicrobiologyFamily Neisseriaceae
Family Neisseriaceae comprises the generaNeisseria,
Moraxella,
Kingella,
Acinetobacter
Genus Neisseria
Important spp.Neisseria meningitidis
Neisseria gonorrhoeae
Some spp. are commensal such as
Neisseria lactamica
Neisseria bacilliformis
Microscopical appearance
Gram ( -ve) arranged in pairs measuring 0.6-0.8 µmCocci are kidney shape or coffee-bean with flat or concave adjacent sides.
N meningiditis has a capsule
N gonorrhoeae has no capsule
N gonorrhoeae
Neisseria gonorrhoeae is the cause of the sexually transmitted disease gonorrheaThis organism is relatively fragile and is susceptible to temperature changes, drying, UV light, and some other environmental conditions.
It is an obligate human pathogen
These organisms are aerobic, strongly oxidase-positive, have an oxidative metabolism, and are fastidious.
Structure of Neisseria gonorrhoeae
Pili, hair-like filament, extend several micrometers from its cell surface and has a role in adherence.
The outer membrane is composed of proteins, phospholipid & lipopolysaccharides(LPS).
Neisserial LPS is unique in that it has highly-branched basal oligosaccharide structure and the absence of repeating O-antigen subunits. Thus, they are referred to as lipooligosaccharide (LOS).
Major outer membrane porin protein (Por P).
Rmp is an outer membrane protein found in all strains of N. gonorrhoeae.I t does not undergo antigenic variation and is found in a complex with Por and LOS.
Pathogenesis and antigenic Structure of Neisseria gonorrhoeae
Successful attachment is the key to the organism ability to cause disease.Attachment of gonococci to mucosal cells is mediated by pili.
There is Opa protein located in the outer membrane, responsible for tight adherence to host cells and invasion of epithelial cells.
The pathogenic mechanism involves the attachment of the bacterium to nonciliated epithelial cells and the production of lipopolysaccharide endotoxin.
Cont,
After attachment, the gonococci enter epithelial cells by a process called parasite-directed endocytosis which is similar to (phagocytosis ), gonococci are not destroyed within cells.Then the gonococci will be released by exocytosis into subepithelial cells.
The outer membrane porin protein ( Por) allows the gonococci to survive inside the phagocytes.
Cont,
Lipo-oligosaccharide (LOS) has profound effect on the virulence of this bacteria, it stimulates the production of tumor necrosis factor (TNF) which causes cell damageNeisseria gonorrhoeae releases soluble fragments of peptidoglycan. These molecules are implicated in the pathogenesis of different forms of gonococcal infection. It is toxic for fallopian tube mucosa leading to intense inflammatory reaction.
Strains of N gonorrhoaea produce IgA protease which cleave the heavy chain of IgA present on the mucus membrane.
Clinical features
Neisseria gonorrhoeae infections are acquired by sexual contact and usually affect the mucous membranes of the urethra in males and the endocervix and urethra in females.In males, infection is usually in the form of urethritis with dysuria and yellowish discharge.
A relatively large number of cases are asymptomatic.
In females, Endocervical infection is characterized by vaginal mucopurlent discharge.
Infection can be asymptomatic in women (50% of cervical infection).
It may cause endometritis, salpengitis.
In a small number of cases, disseminated gonococcal bacteremia, characterized by fever, chill, skin lesion and arthralgias.
Cont,
Ocular infection ( ophthamia neonatorum) occurs most commonly in neonates who are exposed to infected secretion in the birth canal
Lab diagnosis of Neisseria gonorrhoeae
Clinical specimens are pus discharge taken from urethra, cervix, synovial fluid, conjunctiva and blood.
Direct Gram stain of urethral or endocervix may reveal the presence of gram –ve intracellular diplococci which is diagnostic in males
In females, culture should be done.
Direct gram stain of smear from urethral discharge
Cultivation
Neisseria grow well on 5% sheep blood agar and chocolate agar.Other selective medium is Thayer-Martin agar, it is chocolate agar with enrichment supplement and colistin to inhibit gram –Ve bacteria vancomycin to inhibit gram +Ve and nystatin to inhibit fungi.
Agar plates should be incubated at 35-37ºC for 72 hrs in a CO2 enriched humid atmosphere as this m.o. need CO2 (3-7%). This can be achieved by candle jar or CO2 incubator.
The colonies are non-pigmented, non-hemolytic ,colonies are small, grayish and transparent. Older colonies are large with opaque raised center and thin transparent margin
The m.o. can be diagnosed after growth by gram stain and oxidase test ( they are oxidase test: POSITIVE).
Further identification of the spp. can be done by sugar fermentation test.
Neisseria on chocolate agar
Antimicrobial therapy
Penicillin no longer drug of choice due to:
Continuing rise in the Plasmid-encoded beta-lactamase production and chromosomally-mediated resistance
Alternative drugs are ceftriaxone, cefixime or fluoroquinolone
Combined with doxycycline or azithromycin for dual infections with Chlamydia
Chemoprophylaxis of newborns against opthalmianeonatorum with 1% silver nitrate, 1% tetracycline, or 0.5%erythromycin eye ointments
Treatment of newborns with opthalmia neonatorum with ceftriaxone.
No effective vaccine yet exist.
Neisseria meningitidis
Usually inhabit the human nasopharynx without causing detectable disease. This carrier state acts as a reservoir for infection.5-30% of normal individuals are carrier of this m.o. at any given time, yet few develop meningococcal disease.
The attack rate is higher in children peaking at 5 yrs and 4-14 yrs of age.
This infection occurs sporadically and in epidemics.
It is an absolute human pathogen.
Classification and antigenic types
N meningitidis are grouped according to the antigenic character of the cell capsular polysaccahride.The capsule is associated with virulence of the m.o.
13 serotypes have been identified.
The most important are A,B, C, Y and W-135, they account for about 90% of all infections.
Pathogenesis
The bacteria are spread via respiratory droplets.
M.O. attach to non-ciliated columnar epithelial cells
Attachment is mediated by pili.
Invasion of the mucosal cells occurred by a mechanism similar to that described for gonococci.
Antiphagocytic polysaccharide capsule allows systemic spread in absence of specific immunity.
Hyperproduction of meningococcal lipooligosaccharide is highly toxic.
There will be blood stream invasion.
Then m.o. enters the CNS.
It has protease enzyme that cleaves IgA.
Clinical manifestation
Acute meningococcemia is more serious and is often complicated by meningitis . There will be fever, chill, malaise, headache, vomiting, signs of meningeal inflammation.Petechiae or purpura in skin occurs in 30-60% of patients.
Fulminant meningococcimia occurs in 5-15% of cases characterized by high fever, delirium, widespread purpuric skin rash. It is associated with a high mortality rate.
Lab diagnosis
Clinical specimens are CSF, skin rash and blood.Large numbers of encapsulated, small, gram-negative diplococci and polymorphonuclear leukocytes(PMN’s) can be seen microscopically in cerebrospinal fluid (CSF)
Transparent, non-pigmented nonhemolytic colonies on chocolate blood agar with enhanced growth in moist atmosphere with 5% CO
Oxidase-positive
Acid production from glucose and maltose but not from other sugars.
Antimicrobial therapy
Penicillin is still the drug of choice as B- lactamase production is extremely rare.
Other drugs are third generation cephalosporins and chlormphenicol.
Prevention
A single dose vaccine contains polysaccharide capsular antigen of N. menigiditis gr. A, C, Y and W-135.
Chemoprophylaxis for close contacts of patient with this disease is indicated such as rifampicin, ciprofloxacin and ceftriaxone.